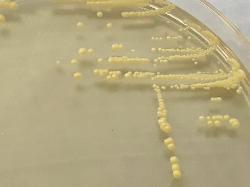

| Citricoccus spp. (C. parietis / C. zhacaiensis) Gram-positive cells |
| Citricoccus spp. (C. parietis / C. zhacaiensis) yellow colonies on Mueller-Hinton agar |
| Citricoccus parietis |
Taxonomy
Morphology
Cultural characteristics
Biochemical characters
Ecology
Pathogenicity
References
Phylum Actinomycetota, Class Actinomycetes, Order Micrococcales, Family Micrococcaceae, Genus Citricoccus, Citricoccus parietis
Schafer et al. 2010.
Schafer et al. 2010.
Gram-positive cocci, 1 µm in diameter. Non-motile. Non-sporeforming.
Colonies are yellow-pigmented, glistening, circular and opaque. Growth was
observed at 4-36 ºC (but not above that temperature), at pH 6.5-12.0, with optimum
growth at pH 8.0-9.0, and in 1-10% NaCl. Good growth occurs after 3 days incubation
on tryptone soy agar, R2A agar and nutrient agar at 25-30 ºC.
observed at 4-36 ºC (but not above that temperature), at pH 6.5-12.0, with optimum
growth at pH 8.0-9.0, and in 1-10% NaCl. Good growth occurs after 3 days incubation
on tryptone soy agar, R2A agar and nutrient agar at 25-30 ºC.
Isolated from the wall of a house colonized with mould, in Jena, Germany.
Undetermined.
- Schafer J., Martin K. and Kampfer P.: Citricoccus parietis sp. nov., isolated from a mould-colonized wall and emended description of
Citricoccus alkalitolerans Li et al. 2005. Int. J. Syst. Evol. Microbiol., 2010, 60, 271-274.
Positive results for catalase and oxidase.
Can utilize azelate, glutarate, L-histidine, putrescine, suberate, acetate,
4-hydroxybenzoate, L-phenylalanine, propionate, L-serine, cisaconitate, L-aspartate,
citrate, fumarate, D-glucose, 3-hydroxybenzoate, DL-lactate, DL-3-hydroxybutyrate,
L-leucine, L-malate, D-maltitol, maltose, D-mannose, 2-oxoglutarate,
L-phenylacetate, L-proline, pyruvate, sucrose and trehalose.
No utilization of trans-aconitate, L-alanine, 4-aminobutyrate,
N-acetyl-D-galactosamine, N-acetyl-D-glucosamine, D-adonitol, beta-alanine,
L-arabinose, arbutin, cellobiose, D-fructose, D-galactose, myo-inositol, itaconate,
D-mannitol, melibiose, mesaconate, L-ornithine, L-rhamnose, ribose, D-sorbitol,
sucrose, L-tryptophan and D-xylose.
Can utilize azelate, glutarate, L-histidine, putrescine, suberate, acetate,
4-hydroxybenzoate, L-phenylalanine, propionate, L-serine, cisaconitate, L-aspartate,
citrate, fumarate, D-glucose, 3-hydroxybenzoate, DL-lactate, DL-3-hydroxybutyrate,
L-leucine, L-malate, D-maltitol, maltose, D-mannose, 2-oxoglutarate,
L-phenylacetate, L-proline, pyruvate, sucrose and trehalose.
No utilization of trans-aconitate, L-alanine, 4-aminobutyrate,
N-acetyl-D-galactosamine, N-acetyl-D-glucosamine, D-adonitol, beta-alanine,
L-arabinose, arbutin, cellobiose, D-fructose, D-galactose, myo-inositol, itaconate,
D-mannitol, melibiose, mesaconate, L-ornithine, L-rhamnose, ribose, D-sorbitol,
sucrose, L-tryptophan and D-xylose.
(c) Costin Stoica

| Antibiogram |
| Encyclopedia |
| Culture media |
| Biochemical tests |
| Stainings |
| Images |
| Movies |
| Articles |
| Identification |
| Software |
| R E G N U M PROKARYOTAE |


| Back |